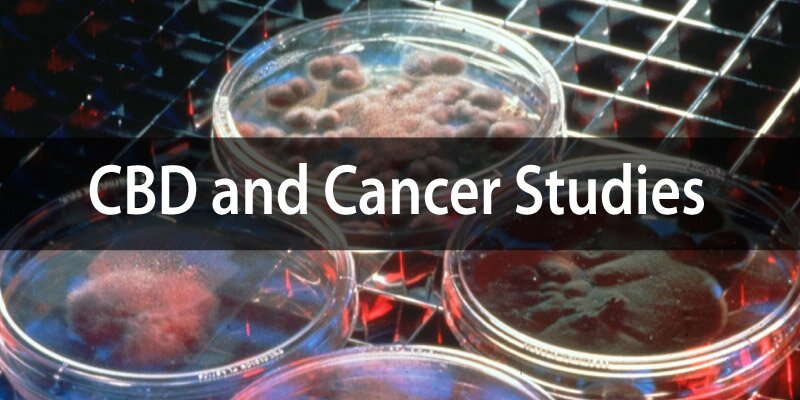
CBD and cancer studies

CBD for Alzheimer’s and Dementia Studies – Summarized List
As you look through these studies on CBD for Alzheimer’s and Dementia, it becomes apparent that cannabidiol is very beneficial for protecting our neurons and brain cells, and helping to rebuild them as well. Let’s look at the studies…